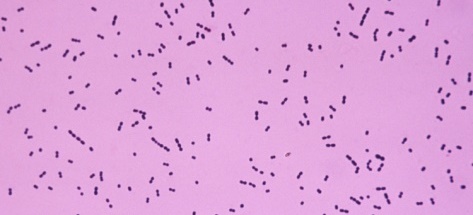
streptococcuspneumoniae

MORGAN’ın Drosophila üzerindeki deneylerinden sonra kromozomların kalıtım birimleri olduğunun açıklığa kavuşturulmasıyla, kromozomların yapısını oluşturan proteinler ve nükleik asitler kalıtımın sağlanmasında en büyük iki aday olarak ortaya çıkmıştır.
1940’lara kadar büyük çeşitlilik göstermeleri ve özgül işlevlere sahip olmaları nedeniyle proteinlerin kalıtsal materyal olarak görev yaptıkları düşünülüyordu. Çünkü bu dönemde nükleik asitler hakkında bilinenler son derece azdı.
Bunun yanı sıra nükleik asitler, canlılardaki büyük çeşitliliği açıklayamayacak kadar homojen bir yapı sergiliyorlardı.

Nükleik asitler, ilk kez 1869 yılında Friedrcih MIESCHER tarafından akyuvar hücreleri ve som balığı spermlerinde keşfedilmiş olup, ismini de hücre çekirdeğinde bulunmasından dolayı almıştır. Ancak bugün, nükleik asitlerin sadece çekirdekte değil hücrenin diğer kısımlarında da bulunduğu bilinmektedir.
Nükleik asitlerin DNA ve RNA olmak üzere iki tipi mevcuttur.
DNA’nın Genetik Rolünün Keşfi

DNA’nın genetik rolünün keşfi, 1928 yılında Frederick GRIFFITH tarafından yapılan deneyle başlamıştır.
Griffith, deneyinde memeli hayvanlarda zatürreye sebep olan Streptococcus pneumoniae bakterisini kullanmıştır.
Bu bakterinin oluşturduğu kolonilerin şekline göre adlandırılan iki faklı suşu mevcuttur.
S tipi olarak adlandırılan kapsüllü olanları patojeniktir ve zatürreye sebep olur.
Kapsül bulundurmayan R tipi bakteriler ise hastalığa neden olmaz.
Griffith’in bu bakteri suşları ile yaptığı deneyler şöyle özetlenebilir.
S tipi bakteriler fareye enjekte edilmiş ve fare zatürreden ölmüştür.
R tipi bakteriler fareye enjekte edilmiş ve fare yaşamına devam etmiştir.
S tipi bakteriler ısıtılarak öldürülmüş ve ardından fareye enjekte edilmiş, fare yaşamına devam etmiştir.
Isıtılarak öldürülmüş S tipi bakteriler, canlı R tipi bakteriler ile karıştırıldıktan sonra bu karışım fareye enjekte edilmiş beklenenin aksine fare ölmüştür.
Son deneyde ölen farenin kanından alınan örneklerde S tipi bakterilere rastlanmıştır.
O halde öldürülen S tipi bakterilerin sahip olduğu bir molekül, R tipi bakterileri dönüşüme uğratarak onlara kapsül yapma, dolayısıyla hastalık yapma yeteneği kazandırmıştır.
Bu şekilde, canlının genetik yapısının dışarıdan alınan DNA parçası ile değiştirilmesi olayına transformasyon denir.
Kısaca, Griffith’in deneyinde ölü S tipi bakteriler, canlı R tipi bakterileri transformasyona uğratmıştır.
Grifftih’in bu deneyi, hücrede kalıtsal bilgi taşıyan bir molekül bulunduğunu ortaya koymuş, ancak bu molekülün ne olduğuna dair bir bilgi ortaya koyamamıştır.

Oswald AVERY ve arkadaşları, Griffith’in deneylerinde kullandığı patojen S tipi bakterileri ısıtarak öldürmüş ve ardından bakterinin yapısını oluşturan değişik kimyasal madde gruplarını saflaştırmıştır.
S tipi bakterilerin saflaştırılan kimyasal madde grupları ayrı ayrı canlı R tipi bakterilerle karıştırarak farelere enjekte edilmiş ve transformasyona neden olan madde tespit edilmeye çalışılmıştır.
S tipi bakterilerin DNA’sı ile R tipi canlı bakterilerden oluşan karışım fareye enjekte edildiğinde fare zatürreden ölmüştür.
AVERY ve arkadaşları 14 yıl süren deneylerinin ardından, 1944 yılında hücrenin genetik bilgisini taşıyan molekülün DNA olduğunu açıklamışlardır.
Bu deney, o tarihe kadar genel olarak kabul gören görüşe ters sonuçlar vermiş ve bilim adamları tarafından şüpheyle karşılanmıştır. Ancak genetik bilgiyi taşıyan moleküllerin proteinler değil DNA olduğu bakteri virüsleri ( faj ) ile yapılan deneylerle kesin şekilde ortaya konmuştur.

Bakteriyofajlar, DNA ve protein kılıftan oluşmuş oldukça basit yapılar olup enfekte ettikleri bakteri hücrelerini bir faj fabrikasına dönüştürebilirler.

1952 yılında CHASE ve HERSHEY, T2 fajı olarak bilinen virüsü ve Escherichia coli bakterilerini kullandıkları deneylerinde şu yolu izleyerek hücrelerdeki kalıtsal materyalin DNA olduğunu ortaya koymuşlardır.
Protein molekülleri kükürt içerdiği halde, DNA molekülleri kükürt içermez. O halde fajın protein kılıfı radyoaktif kükürt izotopu ( 35S ) ile işaretlenebilir.
T2 fajı sadece radyoaktif kükürt taşıyan E. coli hücreleri içinde çoğaltılarak protein kılıflar işaretlenmiştir.
T2 fajları radyoaktif fosfor ( 32P ) taşıyan E. coli hücreleri içinde çoğaltılarak faj DNA’ları işaretlenmiştir.
Protein kılıfı radyoaktif kükürt, DNA’sı ise radyoaktif fosfor ile işaretlenen fajların E. Coli hücrelerini enfekte etmesi sağlanmış, daha sonra fajlar ve bakteriler birbirlerinden ayrılmıştır.
Bakterilerde, radyoaktif kükürte değil, radyoaktif fosfora rastlanması bakterinin içerisine girerek onu bir faj fabrikası haline çeviren kalıtım molekülünün DNA olduğunu açıkça ortaya koymuştur.
PDF DOSYASI İÇİN




